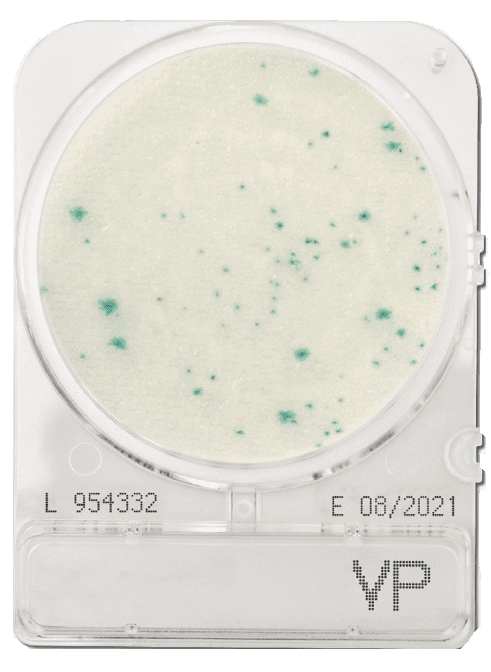

It is considered a release parameter for seafood, shellfish, and seafood-based products.
Vibrio parahaemolyticus is a pathogen which can grow in salt water and can contaminate all types of seafood and shellfish. Infection can occur through the ingestion of raw or undercooked seafood and can cause acute gastroenteritis.
As such, Vibrio parahaemolyticus monitoring and detection is used at each step of food safety testing in the food production
QC process.